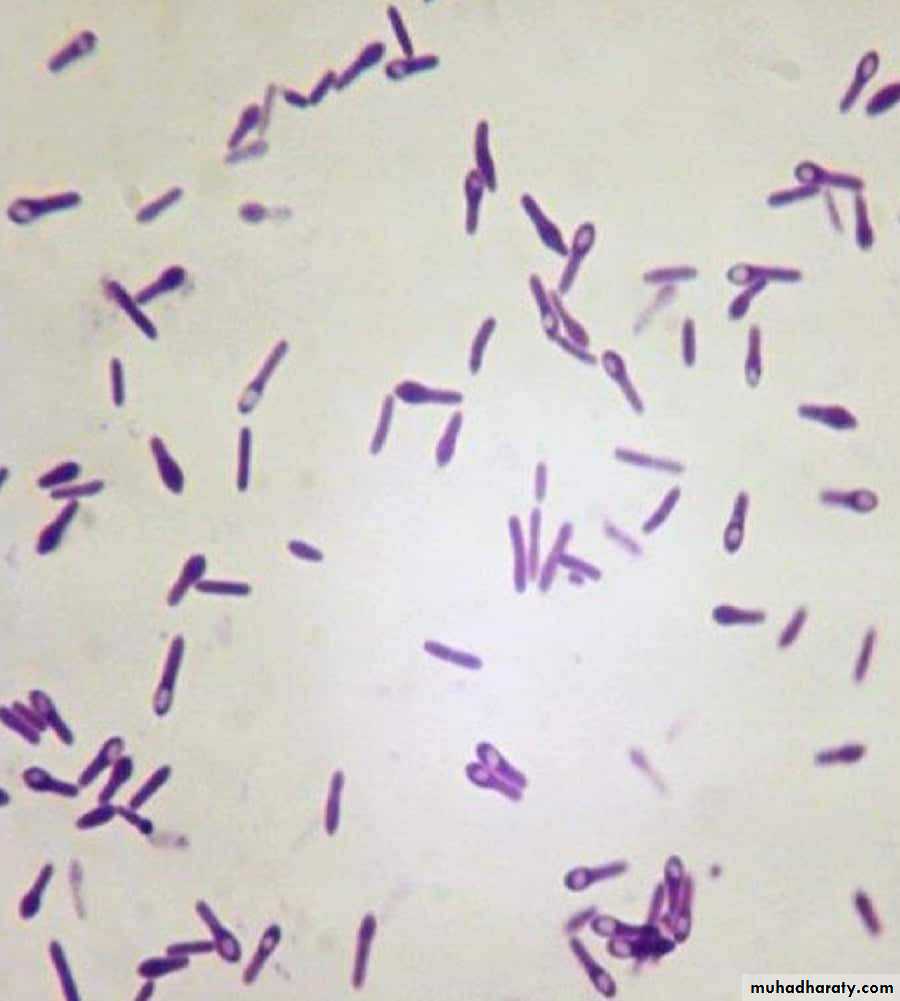
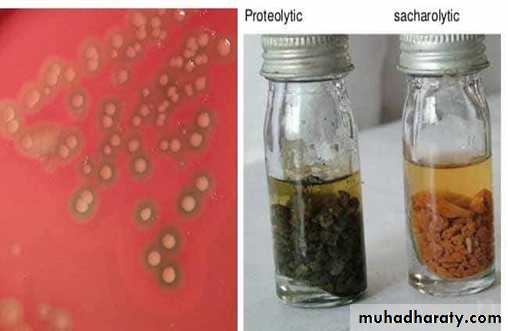
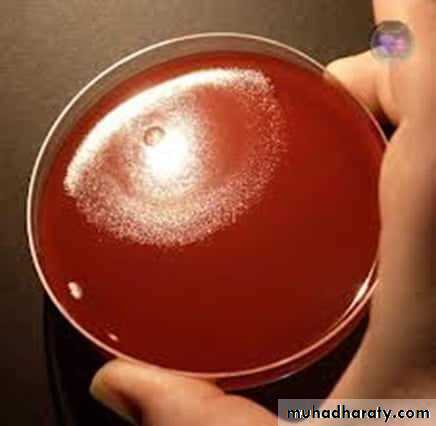
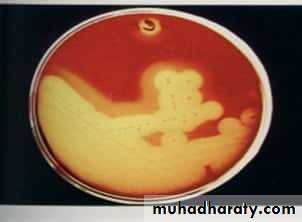
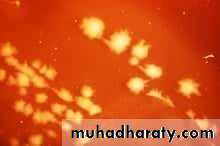
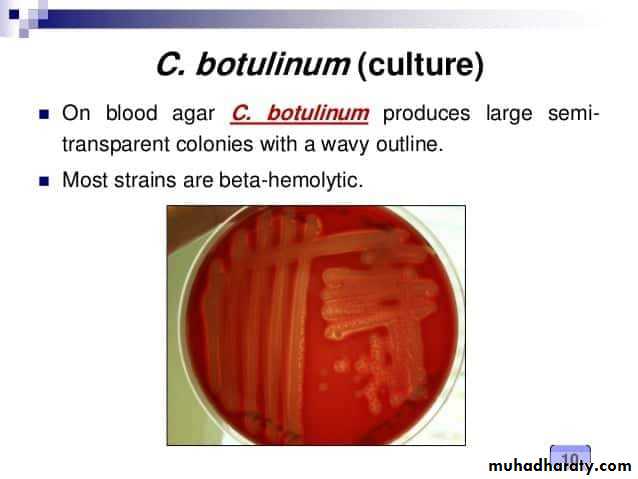

Genus : Clostridium
Clostridium species :
** Large Gram – positive rods, ( 3-10 ) µ X ( 0.5-1.4 ) µ.** Produces bulging ( projecting ) spores ( Cl. Perfringens rarely produce spores ), { size, shape and location of endospores } used for species differentiation.
** Anaerobic, some are aerotolerant.
** Motile by means of peritrichous flagella, except Cl. Perfringens.
** Require enriched media for growth e.g. : sodium thioglycollate broth, Robertson´s cooked meat broth and litmus milk medium.
** They are non – capsulated except Cl. Perfringens.
** Most species produce ß – type of haemolysis on blood agar.
Cultural characteristics :
A) Fluid Thioglycollate Medium ( FTM ) :** Is a reducing medium & supports aerobic and anaerobic bacteria, it contains:
** Sodium Thioglycollate reacts with molecular oxygen keeping free oxygen levels low ( reduces O2 to H2O ).
** Resazurin ( dye ) as an oxidation – reduction indicator which produces :
1. Pink color in an oxidized medium ( containing O2 ).
2. Colorless in reduced medium ( medium anaerobic ).
B) Robertson´s Cooked Meat Medium :
** It is anaerobic medium due to presence of : meat particles ( prepared from heart muscles ) which contain hematin, glutathione and sulfhydryl groups that acts as reducing agents and more available in denatured protein therefore, the meat particles are cooked for use in the medium.**Reactions on cooked meat medium:
1. Saccharolytic reaction :
Causes fermentation of the muscle glycogen with production of turbidity, acid, gas bubbles and the meat particles remain intact.
2. Proteolytic reaction :
Causes digestion of meat particles leading to formation of black, foul smelling sulfur compounds.
C) Litmus Milk Medium :
** It is a multi – purposed medium distinguish between different species of bacteria, contains the lactose ( milk sugar ), casein ( milk protein ) { bacterium can use one of these, both of these, neither of these } and litmus ( pH indicator ).** Sugar users will make ( acid reaction ) causing a change to ( pink ), whereas casein protein users will produce ( alkaline reaction ) causing a change towards ( blue ), and if the casein is completely hydrolyzed, NH3 is released and the medium turns a clear brown, in addition sometimes the litmus indicator get reduced and becomes white , some organisms produce enzyme renin ( curd formed ) and gas in the curd.
Some Clostridium species of Medical Importance :
A) Clostridium tetani ( Tetanus ) :** Vegetative cell : slender bacilli ( 4 – 8 µ X 0.5 µ ), motile by peritrichous flagella and non capsulated.
** Spores : spherical, terminal gives ( drum stick appearance or tennis racket ).
** On blood agar : it produces a fine film of growth ( tiny colonies with rhizoids ), on fresh blood agar it´s hemolytic ( alpha first followed by beta hemolysis ), swarming due to it´s motility.
** Grows strictly anaerobic in sodium thioglycollate broth.
** Grows well in cooked meat broth and produces turbidity gas, meat is not digested turns black.
** On litmus milk medium : no ferments lactose.
** Pathogenic bacterium that causes tetanus.
B) Gas Gangrene Group :1. Clostridium welchii ( Cl. perfringens ):
** Vegetative cell : relatively large bacilli with blunt ends ( 5µ X 1.4 µ ), non motile and capsulated in animal tissues.** Spores : oval, sub terminal and non bulging.
** On blood agar : it produces smooth, large, regular, convex and slightly opaque colonies, and zone of complete hemolysis ( beta hemolysis ) surrounded by wider zone of incomplete hemolysis ( alpha hemolysis ).
** Grows strictly anaerobic in sodium thioglycollate broth.
** In cooked meat broth it produces gas and saccharolytic ( meat is not digested ).
** On litmus milk medium : ferments lactose with acid ( milk clot which is ruptured and broke down into pieces forming stormy clot ) and gas production.
** Pathogenic bacterium that causes gas gangrene and food poisoning.
2. Clostridium septicum :
** Vegetative cell : short, stout bacilli ( 3 – 10 µm ) X ( 0.6 – 1.0 µm ), motile by peritrichous flagella , in tissues it develops into large swollen “ citron bodies ”.** Spores : oval, central or sub terminal and bulging.
** On blood agar : it produces circular colonies with rhizoid or irregular margins with beta hemolysis.
** Grows facultative anaerobic in sodium thioglycollate broth.
** In cooked meat broth it produces gas and saccharolytic ( meat is not digested ).
** Pathogenic bacterium that causes gas gangrene.
3.Clostridium oedematiens : ( Cl. Novyi )
** Vegetative cell : bacilli ( 5 µm X 1.4 µm ), motile and non capsulated.** Spores : large, oval, central or sub terminal and bulging.
** Grows strictly anaerobic in sodium thioglycollate broth.
** In cooked meat broth it produces gas and saccharolytic ( meat is not digested ).
** Pathogenic bacterium that causes gas gangrene.
C) Clostridium botulinum : ( food poisoning – botulism )
** Vegetative cell : large bacilli ( 4 – 6 µm ) X ( 0.9 – 1.2 µm ), motile by peritrichous flagella and non capsulated.** Spores : oval, central or sub terminal and bulging.
** On blood agar : it produces, semi transparent colonies with a wavy outline, and zone of beta hemolysis.
** Grows strictly anaerobic in sodium thioglycollate broth.
** In cooked meat broth it´s proteolytic and non proteolytic.
** On litmus milk medium : non fermenters.
** Pathogenic bacterium that causes botulism disease.
Selected Techniques for the Cultivation of Anaerobes :
1. Using media containing reducing agents, that reacts with oxygen and reduces it to water, e.g. sodium thioglycollate, ascorbic acid, strips of iron.
2. Anaerobic Jar : like McIntosh and Filde´s anaerobic jar with a disposable envelope containing chemicals generate H2 and CO2 when water is added ( Gas Pak system ).
3. Shake culture technique : nutrient agar is melted, cooled to approximately 45°C, inoculated with microorganisms and shaking to distribute contents evenly, incubation of the resolidified culture allows the development of separated colonies especially obligate anaerobes.
4. Using potassium hydroxide and pyrogallol for the absorption of oxygen in the container in which the m.o. has been inoculated ( like Buchner´s tube ).
5. Other method : include the paraffin plug technique a tube of thioglycollate broth is heated for several minutes, cooled quickly then inoculated and a layer of vaspar is laid over the surface of the medium.